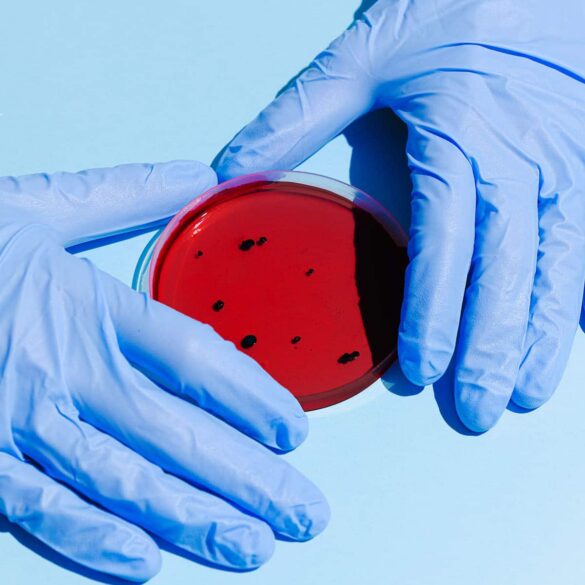

2026 Live Polls Updated Mar 21, 2026 U.S. SENATE Brown (D) 46.9% Husted (R)* 46.4% TOSS-UP (+0.5) GOVERNOR Acton (D)...
Of the four fundamental interactions, gravitation is the dominant at astronomical length scales. Gravity effects are cumulative; by contrast, the...
Cream skimmed from milk may be called “sweet cream” to distinguish it from cream skimmed from whey, a by-product of...
Of the four fundamental interactions, gravitation is the dominant at astronomical length scales. Gravity effects are cumulative; by contrast, the...
Of the four fundamental interactions, gravitation is the dominant at astronomical length scales. Gravity effects are cumulative; by contrast, the...
By astronomical convention, the four seasons can be determined by the solstices—the points in the orbit of maximum axial tilt...
By astronomical convention, the four seasons can be determined by the solstices—the points in the orbit of maximum axial tilt...
There are a number of different theories and hypotheses regarding early state formation that seek generalizations to explain why the...
Of the four fundamental interactions, gravitation is the dominant at astronomical length scales. Gravity effects are cumulative; by contrast, the...